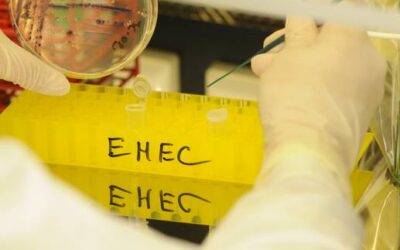
In Mecklenburg-Vorpommern: EHEC-Ausbruch: Unbekannte Infektionsquelle verursacht Besorgnis

Sport Nachrichten
Larsen unterschreibt neuen Vertrag bei Wolves – Wertvollster Norweger nach Haaland & Ødegaard
Kurz nach Festverpflichtung ©IMAGO Nur wenige Wochen nach seiner Festverpflichtung hat Jørgen Strand Larsen (25) einen neuen Vertrag bei den Wolverhampton Wanderers unterschrieben. Das Arbeitspapier ist bis 2030 gültig mit Option auf eine weitere Spielzeit. In der...
Luca Zidane wechselt Staatsangehörigkeit: Will mit Algerien zum Afrika-Cup und zur WM
Sohn von Fußball-Ikone Zinédine ©IMAGO Luca Zidane, Sohn von Fußball-Ikone Zinédine Zidane, hat seine sportliche Staatsangehörigkeit gewechselt, um für Algerien zu spielen. Die Änderung wurde von der FIFA an diesem Freitag genehmigt. Der 27 Jahre alte Torwart war...
Montenegro: Legende Vucinić ersetzt Prosinecki als Nationaltrainer
Prosinecki muss gehen ©IMAGO Der langjährige Serie-A-Profi Mirko Vucinić übernimmt die Nationalmannschaft Montenegros. Der 41-Jährige, der seinen ersten Trainerjob nach dem Karriereende 2017 antritt, folgt auf Robert Prosinecki. Der in Deutschland geborene Kroate...
Eintracht Frankfurt legt hohes Preisschild für Can Uzun fest
Vor Marktwert-Plus im Update ©IMAGO Can Uzun ist einer der Durchstarter der bisherigen Saison. In den ersten fünf Spielen verbuchte der offensive Mittelfeldmann von Eintracht Frankfurt vier Treffer und drei Vorlagen – in bislang jedem Einsatz steuerte er mindestens...
BVB: So erklärt Niko Kovac den Bank-Status von Jobe Bellingham
Zitat von DarjiaZitat von Noergelgnom Manchmal frag ich mich, ob das wirklich der gleiche Niko Kovac ist, der bei Bayern krude Vergleiche mit Autos, die eben nicht schneller fahren können, in die verdutzte Journalistenrunde warf. Das wirkt inzwischen echt souverän und...
Nach Prozess: Dani Alves muss Ex-Klub in Mexiko entschädigen
Früherer Barça-Profi ©IMAGO Ex-Profi Dani Alves muss seinen früheren Verein in Mexiko wegen einer vorzeitigen Vertragsauflösung nach Vorwürfen um eine angebliche Vergewaltigung entschädigen. Dies beschloss der Internationale Sportgerichtshof sechs Monate nach Alves’...
Schlanke Körpermitte: Bauchfett loswerden: Diese 5 Übungen wirken besonders effektiv
Du willst hartnäckigem Bauchfett den Kampf ansagen? Das sind 5 effektive Übungen für eine schlanke Mitte...Weiterlesen
Beschlägt oder verrutscht: Deine Brille nervt beim Laufen? Das sind die Alternativen
Eine rutschende Brille und beschlagene Gläser sind beim Laufen störend. Wir zeigen dir Alternativen zu deiner Alltagsbrille...Weiterlesen
Hollywoodstar und Fitness-Ikone: Wie sich Arnold Schwarzenegger mit veganer Ernährung auch mit 78 fit hält
Arnold Schwarzenegger, mit 78 Jahren immer noch fit, setzt auf eine überwiegend pflanzliche Ernährung, um seine Vitalität und Fitness zu bewahren. Entdecke, was hinter seiner Ernährungsweise steckt...Weiterlesen
Jeder zehnte Deutsche betroffen: Reizdarm erkennen und behandeln – Strategien für mehr Lebensqualität
Reizdarm sorgt für Bauchschmerzen, Blähungen und Verdauungsprobleme. Mit Ernährung, Bewegung und Stressabbau kannst du die Beschwerden lindern...Weiterlesen
In Mecklenburg-Vorpommern: EHEC-Ausbruch: Unbekannte Infektionsquelle verursacht Besorgnis
In Mecklenburg-Vorpommern nehmen die EHEC-Fälle zu, während die Infektionsquelle weiterhin unbekannt ist. Gesundheitsexperten arbeiten intensiv daran, die Ursache zu finden und weitere Infektionen zu verhindern...Weiterlesen
FIFA-Weltrangliste: DFB-Team rutscht aus Top-10 – Harte WM-Lose drohen
Zitat von Buuge Die N11 ist halt ein Spiegelbild der dt. Gesellschaft Man denkt, man gehört noch zu den besten, aber in Wirklichkeit wird man links und rechts abgehängt. Dass man als Bevölkerungsreichstes Land in Europa und Mitgliedstärkster Verband der Welt in den...